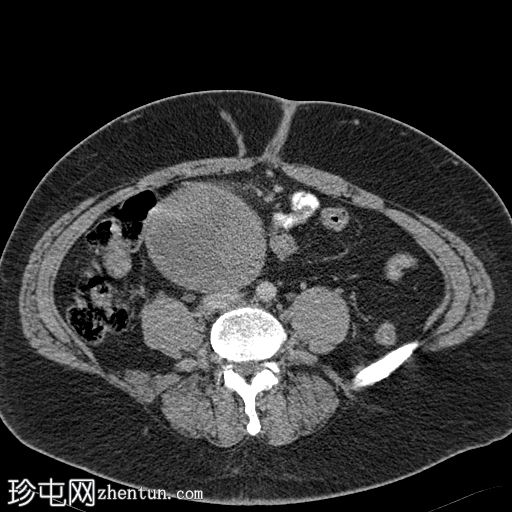
1.jpg

临床表现
患者主诉膀胱刺激症状,下腹部可触及肿块。
患者资料
年龄:55岁
性别:男
CT
轴位增强扫描(门静脉期)
冠状位增强扫描(门静脉期)

矢状位增强扫描(门静脉期)

轴位平扫

轴位肺窗

盆腔内可见一大小为12 x 17 cm的边界清晰的异质性软组织肿块,向下延伸至下腹部。肿块内未见钙化或脂肪密度影。肿块向下推挤膀胱,并牵拉周围肠袢,但无放射学侵犯证据。未见明显淋巴结肿大、腹水或气腹。未见肺部或骨骼局灶性病变。肝脏可见数个小的单纯性囊肿。患者存在少量Bosniak I型肾囊肿,双侧肾盂肾盏系统饱满。曾行胆囊切除术。
照片

切除的盆腔肿块的组织病理学报告显示为恶性孤立性纤维瘤,伴有高分化未分化肉瘤区域。
病例讨论
扫描结果提示非典型平滑肌瘤或平滑肌肉瘤,可能起源于膀胱。患者随后接受了肿块切除术,组织病理学检查显示为恶性孤立性纤维瘤,伴有去分化为高分化未分化肉瘤的区域。 |